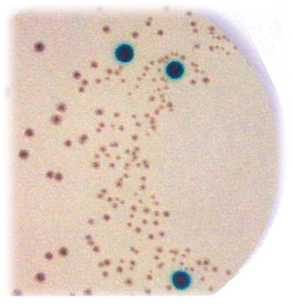

Cronobacter sakazakii, medios de cultivo para su detección
Cronobacter sakazakii, cómo detectar este Enterobacter: medios de cultivo cromogénicos para su detección en comidas para neonatos
Introducción
El patógeno emergente Enterobacter sakazakii (nueva nomenclatura tras encontrarse, por
identificación molecular, 5 especies diferentes dentro del mismo grupo: Cronobacter
sakazakii)…
…es responsable de gravísimas complicaciones en neonatos de menos de 4 semanas
que toman leche contaminada por él, causando hasta un 40-80% de muertes.
Pero también crea enfermedades en personas de todas las edades.
Todo ello exige la ausencia de este patógeno en preparados infantiles que estén destinados a este colectivo, así como en productos lácteos, aunque se trate de un microorganismo ubicuo en el medio ambiente y que por tanto, puede contaminar el biberón en el hospital aunque en la fábrica del alimento se haya constatado su ausencia.
De todas formas es en la industria donde hay mayor riesgo de contaminación,
sobre todo si no hay un riguroso control de la disminución del recuento de enterobacterias
(mejor que coliformes) ambientales.
El comité del Microbiological Risk Assessment (MRA) de la Food and Agriculture Organization (FAO) y la World Health Organization (WHO) proponen clasificar C.sakazakii…
…junto a Salmonella, como un riesgo de categoría “A” y recomiendan que los análisis de las plantas alimentarias incluyan su detección.
Lo primero que se necesita hacer, igual que en Salmonella, es enriquecer para poder detectarlo después en cualquiera de los dos agares cromogénicos disponibles:
1-E. sakazakii (C.sakazakii) CSEB Broth
Caldo selectivo modificado para enriquecimiento selectivo de Enterobacter
sakazakii (Cronobacter sakazakii) en alimentos infantiles y lácteos, según
Norma ISO/TS 22964.
Se trata de un caldo lauryl sulfato modificado con cloruro sódico y
vancomicina que eliminan la flora competitiva (incluido Staphylococcus
aureus y, parcialmente, E.coli).
Incubar 24 h a 44ºC aprox.
Enterobacter sakazakii WDCM00214, Excelente, turbio, crece con colonias verde-azules al
estriar en Cromokit Agar Sakazakii.
Escherichia coli WDCM00013, Excelente, turbio, crece con colonias amarillas (o incoloras
con centro azulado) al estriar en Cromokit Agar Sakazakii
Enterobacter aerogenes WDCM00175, Excelente, turbio, crece con colonias verdes (o
incoloras con centro azulado) al estriar en Cromokit Agar Sakazakii
Klebsiella pneumoniae WDCM00097 Excelente, turbio, crece con colonias amarillas,
grandes al estriar en Cromokit Agar Sakazakii.
Enterococcus faecalis WDCM00087, Inhibido, no turbio
Sembrar los tubos turbios en superficie, en estría, sobre placas de
Sakazakii Cromokit Improved Cristal Violet Agar (MICROKIT DMT315), según ISO/TS 22964:2006.
O bien sobre el Agar selectivo y cromogénico para el aislamiento presuntivo de Enterobacter sakazakii (Cronobacter sakazakii) en alimentos infantiles y lácteos (MICROKIT DMT314), según Normas CSA y DFI.
https://www.microkit.es/fichas/SAKAZAKII-ENRICHMENT-CSEB-BROTH-DMT313.pdf
2-E. sakazakii CROMOKIT IMPROVED CRISTAL VIOLET AGAR
Agar selectivo y cromogénico para el aislamiento presuntivo de Enterobacter
sakazakii (Cronobacter sakazakii) en alimentos infantiles y lácteos, según
Norma ISO/TS 22964:2006, optimizada en 7/2013.
El desoxicolato, el cristal violeta y la temperatura de incubación inhiben el crecimiento de otros microorganismos.
Sembrar en superficie, en estría, a partir del caldo enriquecido CSEB Broth
(DMT313) según ISO/TS 22964:2006
Incubar 18-24 h a 37-41°C aproximadamente.
Observar la aparición de colonias verde-azuladas, que son presuntivas para
E.sakazakii y deben confirmarse resembrando en TSA (BCD011), donde este
microorganismo crece con colonias amarillas.
Enterobacter sakazakii WDCM00214, Excelente, colonias verde-azuladas. PR >50%
Escherichia coli WDCM00013, Excelente, colonias incoloras.
Enterobacter aerogenes WDCM00175, Excelente, colonias incoloras con el centro azulado.
Enterococcus faecalis WDCM00087, Inhibido.
Staphylococcus aureus WDCM 00034, Inhibido.
Identificar con test bioquímicos (ej. Enterotubos ref.MICROKIT 49578619).
https://www.microkit.es/fichas/CROMOKIT-SAKAZAKII-IMPROVED-CRISTAL-VIOLET-AGAR-DMT315.pdf
3-Agar selectivo y cromogénico para el aislamiento presuntivo de Enterobacter sakazakii (Cronobacter sakazakii) en alimentos infantiles y lácteos, según Normas CSA y DFI.
La enzima Beta-D-glucosidasa de este microorganismo reacciona con el sustrato
cromogénico beta-X-glucopiranósido presente en el medio, provocando la aparición de
colonias verde-azuladas en tan sólo 24 horas.
Otras enterobacterias no expresan bien la Beta-D-glucosidasa en este medio, creciendo con colonias crema o púrpura (por el cristal violeta), traslúcidas.
La adición de más agar-agar del tipo cromogénico a la fórmula inicial termoestabiliza el cromógeno, aunque puede llegar a flocular.
El tiosulfato sódico inactiva desinfectantes residuales, como el cloro del agua.
Sembrar en superficie, en estría, a partir del caldo enriquecido CSEB Broth (DMT313)
según ISO/TS 22964:2006.
Incubar 18-24 h a 37-41°C aproximadamente.
Observar la aparición de colonias azules, que son presuntivas para E.sakazakii y deben
confirmarse resembrando en TSA (BCD011), donde este microorganismo crece con colonias
amarillas.
Enterobacter sakazakii WDCM00214, Excelente, colonias azules.
Escherichia coli MWDCM00013, Excelente, colonias amarillas.
Enterobacter aerogenes WDCM00175, Excelente, colonias verdes.
Klebsiella pneumoniae WDCM00097 Excelente, colonias amarillas, grandes.
Enterococcus faecalis WDCM00087, Inhibido.
https://www.microkit.es/fichas/CROMOKIT-SAKAZAKII-AGAR-DMT314.pdf
Identificar con test bioquímicos (ej. Enterotubos ref. MICROKIT 49578619):
https://www.microkit.es/fichas/Enterotubos.pdf
Solicite precios actualizados en microkit@microkit.es
Haga sus pedidos de todas estas soluciones en pedidos@microkit.es